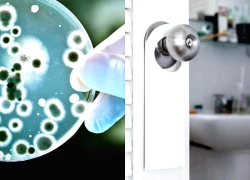

Đừng trồng 8 loại cây này trong nhà – tưởng đẹp mà hóa rước họa, ai từng trồng đều phải “hối hận muốn khóc”!
Dưới đây là 8 loại cây nhìn thì quyến rũ nhưng trồng xong chỉ muốn đào lên ngay, theo chia sẻ của các chuyên gia cảnh quan và người trồng thực tế.
1. Hoa tử đằng – Thác tím đẹp mơ màng nhưng có thể “xé tường”
Khi nở, hoa tử đằng rủ xuống như dòng suối tím, đẹp đến ngỡ ngàng. Nhưng rễ và thân leo của nó lại cực khỏe chúng len vào mọi khe nứt của tường gạch, bám chặt và gây nứt móng. Nếu nhà bạn không gia cố kỹ, chỉ vài năm là bức tường có thể biến dạng. Trồng hoa tử đằng mà không kiểm soát, coi như… “một tay tự phá tường nhà mình”.
2. Cây leo kèn (Trumpet Creeper) – “Nữ hoàng lấn chiếm” của khu vườn
Hoa đỏ cam rực rỡ, trông như chiếc kèn mùa hè – nhưng đừng để vẻ đẹp đánh lừa bạn. Khi trồng xuống đất, rễ của cây leo kèn lan khắp nơi, xuyên qua nền xi măng và chiếm cả khu vườn. Ba năm sau, bạn sẽ chỉ còn lại một màu cam rực… và không thấy cây nào khác sống sót.
3. Cây đuôi ngựa – Nhỏ mà “phá” lớn
Trông thanh thoát, giống tre mini, nhưng hệ rễ của cây đuôi ngựa có thể ăn sâu tới 3 mét, chui qua tường xi măng, chui cả vào cống thoát nước . Nếu không kiểm soát, nó sẽ mọc tràn từ sân sau ra tận lối đi, khiến bạn dọn đến mệt nghỉ.
4. Bạc hà – “ Cỏ dại đội lốt cây thơm”
Bạc hà có mùi dễ chịu, lại dễ trồng – nhưng đừng bao giờ trồng xuống vùng đất trống! Một khi bén rễ, bạc hà mọc lan nhanh như chớp, hôm nay bạn nhổ, ngày mai nó đã mọc lại. Chỉ sau một mùa mưa, cả sân có thể biến thành “đồng bạc hà bất đắc dĩ”.
5. Tre – Cây phong thủy hay cơn ác mộng xanh?
Video đang HOT
Tre tượng trưng cho khí chất và may mắn, nhưng rễ tre lan cực mạnh, mọc xuyên qua cả bức tường, phá nền, làm nghẹt cống. Nếu muốn trồng tre để lấy bóng mát, hãy chôn rào chắn rễ hoặc trồng trong chậu. Nếu không, chỉ vài năm nữa, bạn sẽ thấy mình sống giữa… “rừng tre trong sân nhà”.
6. Coinwort (cây cỏ đồng xu ) – Nhỏ xinh nhưng rễ dai như thép
Lá tròn xinh xắn, trông hợp decor sân vườn, nhưng rễ của cỏ đồng xu lan rộng và khó diệt hơn cả cỏ dại. Bạn có thể đào hôm nay – mai nó mọc lại. Giống như chơi trò “đập chuột chũi”: bạn mệt, nó thắng.
7. Cây chua me đất – Đẹp mong manh, nhưng lan nhanh khủng khiếp
Cây chua me đất có hoa hồng nhạt đáng yêu, nhưng hạt của nó phát tán theo gió và mọc khắp nơi. Một khi bén rễ, chỉ ba năm là cả vườn bạn sẽ biến thành thảm hồng. Đừng để “mỹ nhân sân vườn” này biến thành “kẻ xâm lấn” đáng sợ nhất.
8. Kim ngân hoa – Thơm ngát nhưng “nghẹt thở”
Mùi hương ngọt ngào của kim ngân khiến ai cũng say mê, nhưng đừng trồng sát tường hay cạnh hoa hồng. Kim ngân phát triển liều lĩnh, quấn quanh mọi cây khác, khiến những giống yếu hơn chết ngạt. Một khi nó leo được lên giàn, bạn sẽ phải dùng kéo và cả… lòng kiên nhẫn để kiểm soát nó.
Lời khuyên phong thủy & chăm cây
Trồng cây hợp hướng: Cây tán lớn nên đặt ở hướng Nam hoặc Đông Nam để hút khí lành, tránh chắn sáng.
Cắt tỉa định kỳ: Giúp khí lưu thông, tránh “u ám” trong nhà.
Chọn cây có năng lượng tích cực: Như trầu bà, kim tiền, lưỡi hổ, lan ý – vừa dễ chăm, vừa tượng trưng cho tài lộc.
Tổng kết: Không phải cây nào đẹp cũng hợp nhà bạn. Một khu vườn “đủ” đôi khi tốt hơn một khu vườn “đầy”. Cây hợp phong thủy là cây khiến bạn thấy dễ chịu, an tâm, và không phải vác cuốc dọn rễ mỗi tuần.
Loại cây càng trồng càng có lộc, nếu chặt đi thì tiền tài tiêu tán, vận khí hao tổn
Việc đặt cây trước nhà không những tạo ra không gian xanh cho nhà của bạn mà còn có thể giúp cải thiện đời sống của gia chủ theo phong thủy.
Dưới đây là loại cây càng trồng càng có lộc.
Cây cam, chanh, quất
Thông thường, cây quất thường được trưng trước nhà vào những ngày Tết truyền thống không chỉ vì làm đẹp không gian Tết, mà còn được tin là sẽ mang may mắn và sức khỏe dồi dào cho chủ nhà. Ngoài ra, chúng còn biểu tượng cho một năm "bội thu" dành cho gia chủ.
Những cây khác chung họ hàng với cây quất như chanh và cam cũng mang một biểu tượng chung là mang đến sự thịnh vượng, may mắn và niềm vui cho các thành viên của gia đình.
Cây tre, trúc
Nếu nhà gia chủ có trúc được trồng trước và sau nhà thì theo phong thủy nó sẽ mang lại điều tốt đẹp cho gia đình.
Tương tự với trúc thì tre cũng mang ý nghĩa tương tự. Và cả hai loài cây này cũng không cần bạn phải chăm sóc quá nhiều bởi nó hoàn toàn có thể tự sống sót được dù điều kiện sống có khó khăn đi nữa.
Trồng cây tre hay trúc sẽ mang lại điều tốt đẹp cho gia đình bạn.
Cây tre là biểu tượng của tuổi thọ bởi nó là loài thực vật luôn xanh tươi quanh năm. Trong bất cứ thời tiết nào vẫn có thể phát triển kể cả điều kiện rất khó khăn.
Cây sung
Cây sung là biểu tượng của sự viên mãn, hạnh phúc tròn đầy. Trong lễ cúng, quả sung luôn có mặt bên cạnh cau trầu, nải chuối, như lời cầu mong cho sự sung túc, may mắn.
Việc trồng sung trước cửa không chỉ thể hiện mong muốn đủ đầy mà còn là cách "rước tài vào nhà". Nếu trồng đúng vị trí (không để chắn lối ra vào) thì cây sung lại mang đến lộc quý cho gia chủ.
Cây ăn quả lâu năm
Không chỉ mang đến bóng mát và những mùa trái ngọt, cây ăn quả lâu năm còn được xem là biểu tượng của sự sinh sôi, phát triển bền vững và tài lộc viên mãn. Trong dân gian, nhiều gia đình thường trồng các loại cây như lựu, hồng, cam, bưởi, táo... ở sân trước hoặc sân sau như một cách "gieo lộc" cho cả nhà.
Mỗi loại quả đều mang một ý nghĩa riêng: Lựu tượng trưng cho con cháu đông đúc, cam thể hiện sự hanh thông, hồng mang đến sự viên mãn đủ đầy.
Điều đặc biệt là phần lớn các loại cây ăn quả này có tuổi thọ rất cao nếu được chăm sóc kỹ lưỡng. Càng sống lâu, chúng càng được xem là "cây giữ lộc" - tích tụ nhiều vượng khí cho gia chủ. Vì vậy, người xưa quan niệm rằng chặt bỏ một cây ăn quả lâu năm chẳng khác nào tự tay cắt đứt con đường tài lộc của gia đình.
Cây mít
Cây mít không chỉ là loại cây ăn trái quen thuộc trong vườn nhà mà còn mang đậm giá trị phong thủy. Dân gian có câu "trồng mít thấy vàng", hàm ý rằng mít không chỉ cho quả ngon mà còn tượng trưng cho tài lộc, của cải đong đầy.
Cây mít không chỉ mang ý nghĩa phong thủy về sự đoàn kết, sum vầy, kiên cường và trí tuệ mà còn mang lại những lợi ích thực tế về kích thước lớn, bóng mát và quả có giá trị kinh tế. Tuy nhiên quan niệm phong thủy cho rằng cây mít mang tính âm nên không trồng trước nhà mà trồng sau nhà mới tốt.
Với thân cây vững chắc, tán lá sum suê và rễ ăn sâu vào lòng đất, cây mít đại diện cho sự ổn định, bền vững và phúc khí lâu dài. Đặc biệt, quả mít thường mọc thành từng chùm gần sát thân cây - điều này được xem là biểu trưng cho sự quây quần, gắn bó, con cháu đông đủ, gia đình hòa thuận.
Tuy nhiên quan niệm phong thủy cho rằng cây mít mang tính âm nên không trồng trước nhà mà trồng sau nhà mới tốt.
Ở một số vùng, người ta rất kiêng việc chặt bỏ cây mít nếu không thật sự cần thiết, bởi quan niệm "chặt mít là chặt lộc". Những cây mít lâu năm trong vườn thường được giữ gìn cẩn thận như một phần gắn bó với vận may và tài lộc của cả gia đình.
Cây cau
Theo phong thủy, cây cau giúp dẫn dắt luồng khí tốt từ bên ngoài vào trong nhà, tránh tà khí và bảo vệ gia đạo bình yên. Nếu nhà bạn từng có cây cau trước cửa do ông bà trồng, hãy trân trọng vì đây là biểu tượng của gia phong vững vàng, con cháu có phúc được trời thương. Việc chặt bỏ có thể khiến vận khí gia đình suy giảm.
Đồng hồ và gương trong nhà: Đặt sai vị trí là rước họa, đặt đúng thì thuận phong thủy, hút tiền vào như nước  Đồng hồ và gương là những vật dụng quen thuộc, nhưng cách đặt chúng trong nhà lại ảnh hưởng không nhỏ đến phong thủy, sức khỏe và sự tiện nghi. Theo kinh nghiệm dân gian của ông bà cùng với góc nhìn của phong thủy, có thể đúc kết được rằng: Đồng hồ có ba nơi không treo, gương có ba vị trí...
Đồng hồ và gương là những vật dụng quen thuộc, nhưng cách đặt chúng trong nhà lại ảnh hưởng không nhỏ đến phong thủy, sức khỏe và sự tiện nghi. Theo kinh nghiệm dân gian của ông bà cùng với góc nhìn của phong thủy, có thể đúc kết được rằng: Đồng hồ có ba nơi không treo, gương có ba vị trí...
 Công an trao trả iPhone 17 Pro Max cho hot girl Lào bị móc trộm00:21
Công an trao trả iPhone 17 Pro Max cho hot girl Lào bị móc trộm00:21 Ông bố U70 bơi 4 tiếng qua dòng nước ngập, đem đồ ăn cho con gái ở Thái Nguyên00:46
Ông bố U70 bơi 4 tiếng qua dòng nước ngập, đem đồ ăn cho con gái ở Thái Nguyên00:46 Video: Lũ rút chậm, người dân chèo thuyền tự chế, trèo thang nhận đồ tiếp tế03:36
Video: Lũ rút chậm, người dân chèo thuyền tự chế, trèo thang nhận đồ tiếp tế03:36 Người cha ở Gia Lai thuê múa lân trước mộ con trai 3 tuổi, dân mạng rưng rưng00:54
Người cha ở Gia Lai thuê múa lân trước mộ con trai 3 tuổi, dân mạng rưng rưng00:54![[Clip] Bố bơi ngược bão lũ để con đến kịp sân bay đi du học: 20% sức lực còn lại của bố, phải đổi lấy 200% thành công!](https://t.vietgiaitri.com/2025/10/4/clip-bo-boi-nguoc-bao-lu-de-con-kip-ra-san-bay-di-du-hoc-20-suc-luc-con-lai-cua-bo-phai-doi-lay-200-thanh-cong-700x504-f65-7552100-250x180.webp) [Clip] Bố bơi ngược bão lũ để con đến kịp sân bay đi du học: 20% sức lực còn lại của bố, phải đổi lấy 200% thành công!00:40
[Clip] Bố bơi ngược bão lũ để con đến kịp sân bay đi du học: 20% sức lực còn lại của bố, phải đổi lấy 200% thành công!00:40 Song Hye Kyo có 'tình mới', công khai gọi 'habibi' trên ins, netizen Hàn 'sốc'?03:03
Song Hye Kyo có 'tình mới', công khai gọi 'habibi' trên ins, netizen Hàn 'sốc'?03:03 Victoria Beckham tiết lộ chồng "ép" cô tái hợp Spice Girls, dân mạng xôn xao02:54
Victoria Beckham tiết lộ chồng "ép" cô tái hợp Spice Girls, dân mạng xôn xao02:54 Lan Phương để lộ thái độ của 2 con khi chồng Tây kháng cáo, sắp chia xa?02:55
Lan Phương để lộ thái độ của 2 con khi chồng Tây kháng cáo, sắp chia xa?02:55 2 ngày 1 đêm: HIEUTHUHAI hóa chàng trai đảm đang, bất chấp tạo hình "độc lạ"09:24
2 ngày 1 đêm: HIEUTHUHAI hóa chàng trai đảm đang, bất chấp tạo hình "độc lạ"09:24 Rhymastic tung track mới "diss" Dế Choắt, B Ray "dính chưởng", fan Việt náo loạn02:48
Rhymastic tung track mới "diss" Dế Choắt, B Ray "dính chưởng", fan Việt náo loạn02:48 Vu Mông Lung báo cáo khám nghiệm bị "rò rỉ" dư luận sục sôi và đặt nhiều câu hỏi02:56
Vu Mông Lung báo cáo khám nghiệm bị "rò rỉ" dư luận sục sôi và đặt nhiều câu hỏi02:56Tiêu điểm
Tin đang nóng
Tin mới nhất

Nhà trồng 4 cây này: Rắn sợ run bần bật không dám bén mảng, tài lộc lại ào ào chạy tới

Mẹ tôi nghỉ hưu với lương 5 triệu/tháng - ai cũng lo, nhưng bà sống an nhàn hơn tất cả chúng tôi

Căn bếp 6m trong chung cư 70m của mẹ 8X ở Hà Nội: Nhỏ thôi nhưng khiến ai cũng muốn dọn nhà và nấu ăn ngay lập tức

Mẹ chồng sạch vì chăm, còn tôi sạch vì lười có chiến lược: Hai thế hệ, hai cách dọn nhà khiến ai cũng gật gù

Giận tím người trước 6 thói xấu khiến nhà ngập mùi rẻ tiền, nội thất tiền tỷ cũng chỉ thấy "quê toàn tập"!

Từ người luôn hết tiền giữa tháng: Đổi cách chi tiêu theo 5-2-3, có ngay quỹ 15 triệu sau nửa năm

Tuổi 45 tôi ngỡ ngàng nhận ra: 5 khoản chi tưởng nhỏ mà âm thầm rút cạn tài chính suốt bao năm

Trong hai năm tới muốn mua nhà đừng quên "7 chữ vàng": Mua cũ Mua lớn Đừng mua ba

Từ bảng chi tiêu 8 triệu/tháng đến khoản tiết kiệm đầu tiên: Bước ngoặt quản lý tiền của một phụ nữ U40

Người xưa dạy: Cửa nhà đặt 4 thứ, lộc đến tấp nập, con cháu dễ thành danh

Cây "thần phong thủy", nhà giàu châu Á mê như bị bỏ bùa

Không giao du, không mua sắm bừa bãi, chỉ chọn đồ tốt nhất: Người vợ Nhật Bản biến căn hộ 59m thành cuộc sống thanh lịch đáng mơ ước
Có thể bạn quan tâm

Hình ảnh Lương Bằng Quang có mặt làm việc với Công an TP.HCM
Sao việt
00:13:35 14/10/2025
Bị khán giả tẩy chay, đòi bỏ phim, "nữ chính phim giờ vàng" chính thức lên tiếng giãi bày
Hậu trường phim
00:08:54 14/10/2025
Lan Phương bị tấn công
Phim việt
23:59:32 13/10/2025
Phục sát đất phim Trung Quốc mới chiếu 9 ngày đã lãi 567%, đỉnh cao trác tuyệt không xem phí cả đời
Phim châu á
23:57:12 13/10/2025
Nam tài tử Keanu Reeves 'thoái vai' ông Kẹ trong phim hài mới 'Vận may'
Phim âu mỹ
23:29:24 13/10/2025
Rosé (BlackPink) bị ghét bỏ vì kể chuyện về Bruno Mars
Sao châu á
23:24:59 13/10/2025
Khoảnh khắc ấm áp của gia đình diva Mỹ Linh trên sân khấu Hàn Quốc
Nhạc việt
23:15:09 13/10/2025
2 ngày 1 đêm: Kaity Nguyễn ấm ức bật khóc, được bù đắp đặc biệt từ Kiều Minh Tuấn
Tv show
23:12:16 13/10/2025
Nhìn lại những khoảnh khắc thảm đỏ mang tính biểu tượng của diễn viên Diane Keaton
Phong cách sao
23:09:55 13/10/2025
Đàn cá bơi trong nhà giữa mùa lũ, gia chủ ở Bắc Ninh tiết lộ lý do bất ngờ
Netizen
22:41:05 13/10/2025
 Hội chị em U60 góp hơn 14 tỷ đồng về quê xây biệt thự 700m2 dưỡng già: “Chồng thì đã sống chung cả đời, ở với con cháu không bằng ở với bạn”
Hội chị em U60 góp hơn 14 tỷ đồng về quê xây biệt thự 700m2 dưỡng già: “Chồng thì đã sống chung cả đời, ở với con cháu không bằng ở với bạn”









 Những loại cây nên trồng trước nhà mang lại tài lộc
Những loại cây nên trồng trước nhà mang lại tài lộc Nói thật: Nhét 4 thứ này vào tủ lạnh chẳng khác nào "đào hố chôn mình", rước họa vào thân
Nói thật: Nhét 4 thứ này vào tủ lạnh chẳng khác nào "đào hố chôn mình", rước họa vào thân Đổ muối xuống cống thoát nước, hiệu quả đến không ngờ, tiết kiệm tiền triệu mỗi năm
Đổ muối xuống cống thoát nước, hiệu quả đến không ngờ, tiết kiệm tiền triệu mỗi năm 9 sai lầm nghiêm trọng làm ban công vừa xấu vừa rước họa cho gia đình
9 sai lầm nghiêm trọng làm ban công vừa xấu vừa rước họa cho gia đình 4 tính năng "tự động" của đồ dùng, nhiều người tưởng vừa tiện vừa tiết kiệm điện nhưng dùng lâu gây tác dụng ngược, rước họa cho sức khỏe
4 tính năng "tự động" của đồ dùng, nhiều người tưởng vừa tiện vừa tiết kiệm điện nhưng dùng lâu gây tác dụng ngược, rước họa cho sức khỏe Cây tre 'độc nhất vô nhị' ở Đắk Lắk, trả 100 triệu đồng chủ nhân vẫn không bán
Cây tre 'độc nhất vô nhị' ở Đắk Lắk, trả 100 triệu đồng chủ nhân vẫn không bán Đổ 1 bát muối xuống đường ống thoát nước, cả nhà hưởng lợi, thấy ngay tác dụng kì diệu
Đổ 1 bát muối xuống đường ống thoát nước, cả nhà hưởng lợi, thấy ngay tác dụng kì diệu Tối đi ngủ, bỏ 1 tép tỏi vào bồn cầu, sáng hôm sau điều vi diệu xảy ra, ai ai cũng khen ngợi
Tối đi ngủ, bỏ 1 tép tỏi vào bồn cầu, sáng hôm sau điều vi diệu xảy ra, ai ai cũng khen ngợi 5 loài hoa vừa đẹp vừa chống được trộm, trồng một bụi bên bờ rào nhà nổi bần bật giữa phố
5 loài hoa vừa đẹp vừa chống được trộm, trồng một bụi bên bờ rào nhà nổi bần bật giữa phố Bị trầm cảm, Gen Z lui về làm vườn, biến sân thượng 260m2 thành khu vườn "trên mây" để chữa lành vết thương
Bị trầm cảm, Gen Z lui về làm vườn, biến sân thượng 260m2 thành khu vườn "trên mây" để chữa lành vết thương Phục hồi cống thoát nước cũ bằng công nghệ không đào hở
Phục hồi cống thoát nước cũ bằng công nghệ không đào hở Biệt thự hiện đại 3 tầng đẹp ngỡ ngàng với ý tưởng thiết kế từ bụi tre
Biệt thự hiện đại 3 tầng đẹp ngỡ ngàng với ý tưởng thiết kế từ bụi tre Đừng vứt thứ này xuống cống nữa, bạn sẽ mất tiền triệu vì đã làm nó hằng ngày
Đừng vứt thứ này xuống cống nữa, bạn sẽ mất tiền triệu vì đã làm nó hằng ngày 10 loại cây cảnh khiến bạn nhìn thấy chỉ muốn mua về trồng ngay
10 loại cây cảnh khiến bạn nhìn thấy chỉ muốn mua về trồng ngay Đặt một quả bóng bay vào miệng cống thoát nước, bạn sẽ thấy điều kỳ diệu sau 1 đêm
Đặt một quả bóng bay vào miệng cống thoát nước, bạn sẽ thấy điều kỳ diệu sau 1 đêm Chuyên gia phong thuỷ tiết lộ: Nên trồng đào, tre trúc trước cửa nhà, còn loại cây này thì tuyệt đối không!
Chuyên gia phong thuỷ tiết lộ: Nên trồng đào, tre trúc trước cửa nhà, còn loại cây này thì tuyệt đối không! 6 cách dùng tre trong nhà, không gian 'cực chất', đẹp quyến rũ
6 cách dùng tre trong nhà, không gian 'cực chất', đẹp quyến rũ Mùa hè này uống bia không hết đừng vứt đi, mang vào nhà vệ sinh có tác dụng tuyệt vời
Mùa hè này uống bia không hết đừng vứt đi, mang vào nhà vệ sinh có tác dụng tuyệt vời Những thiết kế "bá đạo" nhất quả đất
Những thiết kế "bá đạo" nhất quả đất Chàng trai khuyết tật "viết" nên điều kỳ diệu từ thân tre
Chàng trai khuyết tật "viết" nên điều kỳ diệu từ thân tre Đặt bàn thờ trong phòng khách nhớ những lưu ý này, điểm xem có mắc lỗi nào không
Đặt bàn thờ trong phòng khách nhớ những lưu ý này, điểm xem có mắc lỗi nào không Nghệ An: Những công trình độc đáo chào đón Noel năm 2020
Nghệ An: Những công trình độc đáo chào đón Noel năm 2020 Ông bà nói: Nhà là gốc của tài - 3 nơi càng sạch thì lộc càng tụ, làm ăn trơn tru như bôi mỡ
Ông bà nói: Nhà là gốc của tài - 3 nơi càng sạch thì lộc càng tụ, làm ăn trơn tru như bôi mỡ Chặt 3 cây ngoài sân, gỡ 4 vật trong nhà: Vận đổi nhanh như tên lửa, dễ giàu to
Chặt 3 cây ngoài sân, gỡ 4 vật trong nhà: Vận đổi nhanh như tên lửa, dễ giàu to Từ căn hộ 34m, cặp vợ chồng khéo cải tạo thành nhà hai phòng ngủ, ai xem cũng thốt lên: "Không thể tin nổi!"
Từ căn hộ 34m, cặp vợ chồng khéo cải tạo thành nhà hai phòng ngủ, ai xem cũng thốt lên: "Không thể tin nổi!" Luôn đóng cửa nhà vệ sinh khi không dùng, tôi hối hận vì 30 năm cuộc đời không biết cách này sớm hơn
Luôn đóng cửa nhà vệ sinh khi không dùng, tôi hối hận vì 30 năm cuộc đời không biết cách này sớm hơn Tôi không có sổ đỏ, không lương hưu - nhưng 3 khoản quỹ nhỏ đã giúp tôi sống nhàn sau 60 tuổi
Tôi không có sổ đỏ, không lương hưu - nhưng 3 khoản quỹ nhỏ đã giúp tôi sống nhàn sau 60 tuổi Một tuần sống tối giản của tôi: Tiêu ít hơn, sống có kế hoạch và bất ngờ thấy mình giàu có theo cách khác
Một tuần sống tối giản của tôi: Tiêu ít hơn, sống có kế hoạch và bất ngờ thấy mình giàu có theo cách khác Lương 15 triệu/tháng, tôi đổi cách chia tiền - 6 tháng sau, tài khoản tiết kiệm đã tăng thêm 20 triệu
Lương 15 triệu/tháng, tôi đổi cách chia tiền - 6 tháng sau, tài khoản tiết kiệm đã tăng thêm 20 triệu Cái hay của việc đi thuê nhà
Cái hay của việc đi thuê nhà Ngân 98 bị khởi tố: Người nhà kịp "rút tên" khỏi công ty Zubu 1 tháng trước
Ngân 98 bị khởi tố: Người nhà kịp "rút tên" khỏi công ty Zubu 1 tháng trước Ngân 98 khai quanh co, nói "quá tin nhà sản xuất"
Ngân 98 khai quanh co, nói "quá tin nhà sản xuất" Vô tình gặp bạn trai ở bữa tiệc, tôi bật khóc khi thấy anh sánh đôi cùng ai
Vô tình gặp bạn trai ở bữa tiệc, tôi bật khóc khi thấy anh sánh đôi cùng ai Lương Bằng Quang liên quan gì đến Ngân 98?
Lương Bằng Quang liên quan gì đến Ngân 98? Ngoại hình phát tướng, sưng phù gây sốc của bà xã Taeyang (BIGBANG)
Ngoại hình phát tướng, sưng phù gây sốc của bà xã Taeyang (BIGBANG) Chân dung cựu Thủ tướng Canada giờ là bạn trai Katy Perry
Chân dung cựu Thủ tướng Canada giờ là bạn trai Katy Perry Những thương vụ của Shark Bình ở "bể cá mập"
Những thương vụ của Shark Bình ở "bể cá mập" Công an triệu tập Lương Bằng Quang
Công an triệu tập Lương Bằng Quang Nữ sinh Đại học Ngoại ngữ ở Hà Nội mất tích: Tìm thấy thi thể cách xa 120km
Nữ sinh Đại học Ngoại ngữ ở Hà Nội mất tích: Tìm thấy thi thể cách xa 120km Tìm được phim Trung Quốc siêu hay sướng hơn trúng số độc đắc: Cặp chính đẹp ác liệt, 3 tỷ người xem chỉ sợ hết
Tìm được phim Trung Quốc siêu hay sướng hơn trúng số độc đắc: Cặp chính đẹp ác liệt, 3 tỷ người xem chỉ sợ hết Diễn viên Việt ly hôn đại gia ngàn tỷ, phải đi bày mâm cúng cô hồn thuê, giờ sở hữu 2 nhà hàng sang trọng
Diễn viên Việt ly hôn đại gia ngàn tỷ, phải đi bày mâm cúng cô hồn thuê, giờ sở hữu 2 nhà hàng sang trọng Tình hình hai nghệ sĩ Việt là anh em ruột mắc ung thư: Sống lạc quan dù 1 người đã di căn tới xương
Tình hình hai nghệ sĩ Việt là anh em ruột mắc ung thư: Sống lạc quan dù 1 người đã di căn tới xương Vụ tài xế 'nóng ruột' vì chờ đoàn đón dâu quá lâu: Người chú đặt xe lên tiếng
Vụ tài xế 'nóng ruột' vì chờ đoàn đón dâu quá lâu: Người chú đặt xe lên tiếng Ngân 98 vừa bị bắt tạm giam là ai?
Ngân 98 vừa bị bắt tạm giam là ai? Phương Oanh không sợ hãi
Phương Oanh không sợ hãi Vợ thiên vương đình đám bị coi như "máy đẻ", sống tằn tiện vì chồng keo kiệt
Vợ thiên vương đình đám bị coi như "máy đẻ", sống tằn tiện vì chồng keo kiệt DJ Ngân 98 bị bắt
DJ Ngân 98 bị bắt Khởi tố chủ nhà hai lần đốt rác trên tầng thượng gây cháy lan tại đường Đê La Thành
Khởi tố chủ nhà hai lần đốt rác trên tầng thượng gây cháy lan tại đường Đê La Thành